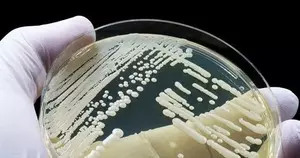

Potentially deadly fungal disease spreading in California
Sacramento, Sep 6 Valley Fever, a fungal disease, has been spreading in California, with warnings from state health authorities about an increased risk through the fall, local news outlets reported.
Valley Fever is caused by breathing in dust from outdoor air containing spores of the Coccidioides fungus. It usually affects the lungs and can cause prolonged symptoms, including cough, fever, chest pain, and fatigue, Xinhua news agency reported quoting local media.
It can also lead to severe diseases, such as meningitis, and even death, according to the California Department of Public Health (CDPH).
The CDPH warned last week that people living in or travelling to the state's Central Valley and Central Coast regions face higher risks. The department was preparing for "another possible increase in Valley fever cases in the coming months."
"If you have a lingering cough and fatigue, please talk to a doctor about Valley fever, especially if you've been outdoors in dusty air in the Central Valley or Central Coast regions," said CDPH Director and State Public Health Officer Tomas Aragon in a news release.
A recent valley fever outbreak has been traced to the Lightning in a Bottle music festival held in May near Bakersfield, California, a local KGET news channel said Thursday, adding that as of August 21, health officials had confirmed at least 19 cases of the fungal infection among festival attendees and workers, with eight individuals requiring hospitalisation.
The CDPH is investigating the outbreak. The electronic dance music festival at Buena Vista Lake in Kern County of California drew approximately 20,000 attendees from May 22 to 27.
The surge in cases was believed to be linked to the festival's dusty conditions, exacerbated by high winds during the event. Festival organisers had implemented dust control measures, including watering the ground and providing free masks, but these efforts appeared insufficient in preventing the outbreak.
Valley fever has been surging in California, with over 9,000 cases reported last year and over 5,000 preliminary cases reported as of July 1, according to the CDPH.
The department said possible causes of this recent increase include winter rains after several years of drought, an increase in soil disturbance activities in high-risk areas, and increased disease recognition.
Though most cases in California are reported from the Central Valley and Central Coast regions, the state Health Department has seen increasing cases outside of these regions, including in the northern Central Valley and Southern California.
Source: IANS